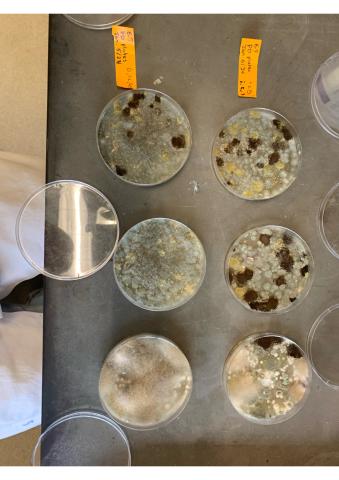
Some samples

Expand each item to read more about the project details of the Climate Action Grant Recipients.
2025 Climate Action Grant Recipients
- Image

- Project: Adventuring into Life Bike Program
- Grant: $1,680
- Project Description: Students in kindergarten through grade 2 at Dallas Elementary took part in a hands-on bike safety and skills program that taught safe riding habits, helmet use, balance, and awareness. By introducing cycling as a fun, active, and sustainable way to travel, the program helped students build confidence while exploring how everyday transportation choices can support healthy people, healthy communities, and a healthier environment.
- Image

- Project: Repair Café
- Grant: $2,000
- Project Description: Through four community repair events, knowledgeable volunteers helped give 363 items a second life, achieving a 61% repair success rate. The initiative reduced waste, diverted materials from the landfill, and empowered participants with practical repair skills and information about responsible recycling options within the community.
- Image

- Project: Propelus Carshare Feasibility Study
- Grant: $2,000
- Project Description: A feasibility study assessed the potential for a carshare service in Kamloops, exploring opportunities to reduce private vehicle ownership, traffic, and parking demand. Volunteers engaged 305 households near a proposed pilot location on Tranquille Road, collecting community feedback to help guide future program development.
- Image

- Project: Climate Action, Resilience and Emotions
- Grant: $2,000
- Project Description: Through youth-led workshops, Climate Action, Resilience and Emotions (CARE) engaged more than 600 students in conversations about the emotional impacts of climate change. The program fostered resilience and hope while equipping participants with tools to process their feelings and take meaningful climate action at individual, collective, and systemic levels.
- Image
- Project: Connecting with the Land: A Holistic Climate Action and Emergency Preparedness Project for Grade 6/7
- Grant: $2,000
- Project Description: Students visited the Climate Connections Trail at West Highlands Park to explore local ecosystems and connect classroom learning with real-world climate change impacts. Through presentations by City staff, they gained a deeper understanding of climate action while supporting ongoing projects and strengthening collaboration with First Nations partners.
- Image

- Project: Families Supporting Water and Land for the Future
- Grant: $1,875
- Project Description: NatureKids engaged more than 130 participants through six family-friendly nature events that explored local ecosystems, biodiversity, and urban green spaces. The program also exceeded its membership goal, growing to more than 140 members, and provided families with resources to support ongoing environmental learning and stewardship at home.
- Image

- Project: Invasive Species Signs
- Grant: $500
- Project Description: Two educational signs were installed in Peterson Creek Park to help raise awareness about invasive species and protect local biodiversity. By promoting simple prevention measures, such as cleaning gear, staying on designated trails, and properly disposing of invasive plants, the project supports healthier ecosystems and informed stewardship of natural areas.
- Image

- Project: Kamloops Community Forest
- Grant: $1,131.39
- Project Description: Upgrades to irrigation equipment and water access improved the efficiency of volunteer tree watering along the Climate Connections Trail at West Highlands Park. The project also engaged community members in tree planting and climate action, demonstrating how collective efforts can support a healthier, more resilient urban forest.
- Image

- Project: Bacterial Degradation of Microplastics in Kamloops Food Waste
- Grant: $2,000
- Project Description: The project successfully created reliable methods for detecting microplastics and growing bacteria that may be able to degrade plastics in compost. Some bacterial strains were able to grow on a food source containing polyethylene terephthalate (PET plastic), suggesting they could help break down plastic waste. These methods provide a foundation for future work to isolate, monitor, and identify bacteria that may help reduce plastic waste.
- Image

- Project: Increasing the Tree Canopy in the Sagebrush Neighbourhood
- Grant: $1,069.62
- Project Description: High school students led a tree-planting project at their school, improving local green space while demonstrating the power of youth-led climate action. The initiative helped build confidence, foster resilience, and inspire positive environmental action throughout the school community.
- Image
- Project: Food Sovereignty Education Program
- Grant: $2,000
- Project Description: Eleven Produce Preservation Workshops at the Stir Food Hub Kitchen taught participants how to can, freeze, and dehydrate local produce, helping reduce food waste and extend access to healthy food year-round. The workshops also built practical skills, supported food security, and fostered community connections through shared learning and knowledge exchange.
2024 Climate Action Grant Recipients
- Image
- Project: Aberdeen Elementary and Sifton Loop Tree Planting and Maintenance Project
- Grant: $1,470
- Project Description: The Aberdeen Elementary Parent Advisory Council teamed up with School District #73 to plant five beautiful maple trees along the west side of the lower field. These trees will not only provide shade for spectators at future sporting events but also help boost local biodiversity and carbon capture, making the school grounds greener and healthier for everyone.
- Image

- Project: Climate Action, Resilience and Emotions
- Grant: $1,760
- Project Description: Be the Change Earth Alliance Society surpassed their goal of eight workshops by delivering ten two-part educational sessions to over 270 students in Kamloops classrooms. These workshops focused on practical actions students can take to reduce their carbon emissions and encouraged critical thinking about sustainable transportation, waste reduction, and the creation of thriving urban ecosystems. Students were also given space to explore their emotions surrounding the climate crisis and to build tools for emotional resilience.The workshops received highly positive feedback from both teachers and students. Among the teachers surveyed, 86% agreed or strongly agreed that their students gained a stronger understanding and greater comfort with climate change concepts. Following the Climate Action Workshops, 80% of students reported feeling more motivated to act on climate change.
- Image

- Project: Restoration of Bestwick to Royal Inland Hospital Trail
- Grant: $1,386
- Project Description: Volunteers came together to regrade 170 metres of trail between Bestwick Drive and the RIH Trail, giving the path a fresh, smooth surface with a carefully layered base and topping. The project not only improved the trail for everyone but also brought the community together, with extra volunteers pitching in to provide lunch and refreshments for the crew.Thanks to these upgrades, the trail is now safer and easier to use in wet and winter conditions, while better drainage and reduced erosion will help it last for years to come.
- Image

- Project: Urban Butler Farm
- Grant: $1,760
- Project Description: Grant funds were used to purchase farm tools and upgrade the irrigation system, enhancing the farm’s role as a public community space. Composting services were offered to The Loop and nearby restaurants, and locals were invited to drop off food scraps for composting on-site.In partnership with the Kamloops Naturalist Club and Kamloops Immigrant Services, the farm hosted a multicultural seed-starting workshop for newcomer youth and families at The Stir, starting 39 seed varieties—some later planted at the farm. Summer Camp students from Kamloops Immigrant Services also visited to harvest produce, plant seedlings, and enjoy nature-based activities like flower necklace making.
Twice-weekly drop-in sessions allowed volunteers to participate in group harvesting and other farm tasks, while additional events such as a botanical art night provided hands-on learning opportunities. Free workshops and field trips welcomed participants of all ages, incomes, and backgrounds, fostering connection, education, and community engagement.
- Image

- Project: Bicycle Repair Stands
- Grant: $1,000
- Project Description: A new bike repair stand and pump have been installed in the Pineview parking lot on Lac Le Jeune Road, giving cyclists a convenient spot to fix their bikes on the go. Maintained by the Pineview network, the station has received great feedback from the community and sparked local teamwork, helping keep both riders and their bikes rolling smoothly.
- Image
- Project: School Garden Beautification and Kamloops Christian School
- Grant: $1,020
- Project Description: Students rolled up their sleeves to help create a vibrant urban gardenand boost local Sustainability Projectbiodiversity. The garden is a hands-on classroom where they learn about starting seeds, planting, watering, and caring for healthy landscapes. High school students prepared the garden beds and installed an efficient irrigation system, making it easy for younger students to plant and tend vegetables, pollinator-friendly flowers, native plants, and herbs—turning learning into action while connecting with nature.
- Image

- Project: Living in Harmony with Woodpeckers
- Grant: $1,760
- Project Description: The Kamloops Naturalist Club started a project to help homeowners protect their buildings from woodpecker damage, which can affect insulation and energy efficiency. Their research showed that providing nesting boxes is a simple and effective solution. The Club focused on building and collecting these boxes, which weredistributed in spring 2025 to homeowners who reported woodpecker problems through an online survey. After the nesting season, the Club will follow up to see how well the boxes helped reduce damage—bringing people and nature together to find practical solutions.
- Project: McDonald Park Shade Tree Planting
- Grant: $0
- Project Description: To provide shade and sequester carbon, the McDonald Park Neighbourhood Association had requested funding to plant trees near the McDonald Dog Park for shade and biodiversity. In the end, the grant funding was not required as City arborists had been planning to purchase and plant trees at this location. Four trees were planted: a honey locust, an autumn blaze red maple, a freeman armstrong maple, and a bur oak.
- Image

- Project: Pollinator Gardens
- Grant: $1,320
- Project Description: Pollinator plants were added to the BC Wildlife Park and Beattie Elementary School to brighten the area with wildflowers, support local food production, and give nature a helping hand. The project also created better migration paths for Monarch butterflies, provided more food, water, and shelter for pollinators, and helped absorb greenhouse gases.
- Image

- Project: Composting at South Sahali
- Grant: $955.94
- Project Description: South Sahali Elementary continued their composting project from 2023, helping students reduce waste, care for the environment, and build a sense of social responsibility. Six classrooms and the staff room actively participated, and on Hot Lunch days, all students were encouraged to compost leftover food and containers. Even the paper bags from the Hot Lunch Program found a second life as liners for the compost bins, showing how small actions can make a big difference.
- Image

- Project: Repair Café
- Grant: $1,640
- Project Description: Repair Café went above and beyond their goal of three workshops by hosting four events, each attracting around 20 volunteers and 64 visitors. About 65% of items brought in were successfully repaired, with many repairs offering hands-on lessons so guests could tackle similar fixes on their own. A big highlight of the events was repairing bicycles and teaching simple bike maintenance. Items that couldn’t be fixed were responsibly sent to recycling depots, keeping materials out of the landfill and supporting a more sustainable community.
- Image
- Project: A microbial perspective on cardboard waste reduction through vermicomposting
- Grant: $1,760
- Project Description: This project explored how adding cardboard to compost affects microbial diversity and the overall quality of compost for agricultural use. By comparing compost with and without cardboard, researchers found that including cardboard—regardless of type—boosts both bacterial and fungal diversity. Beyond improving compost, this approach also helps reduce the amount of cardboard sent to recycling. The project even inspired new goals, focusing on how composting cardboard can further cut down on recycling waste while supporting healthy soil and sustainable gardening practices.
- Image

- Project: Upgrading Recycling
- Grant: $1,760
- Project Description: Valleyview Secondary took a big step toward reducing landfill waste by introducing five new waste diversion stations. Smaller than the old bins, these stations accept a wider range of materials, including mixed recycling, cans, and bottles. The project brought the school community together, with the Life Skills class helping to manage the waste. Going forward, the new bins will make it easier for custodial staff to keep the school clean and sustainable, while teaching students the value of recycling and responsible waste management.
- Image

- Project: Westmount Sustainability Project
- Grant: $1,100
- Project Description: The school launched a recycling and composting program to help students sort organics, flexible plastics, curbside recycling, and garbage. Recycling centers were set up in every classroom, while special collection bins for batteries, felt markers, foam, and metal were available in the office. The program has been a huge success, exceeding its waste diversion goal of 90%—now achieving 95% diversion—and reducing daily garbage to just one bag. This initiative not only keeps the school greener but also teaches students the importance of waste reduction and sustainability in action.
- Image

- Project: Kamloops Community Forest
- Grant: $635
- Project Description: Six trees were planted at West Highlands Park to capture carbon and create a greener, cooler space for the community. A special community planting event invited residents to get involved, connect with neighbours, and build intergenerational relationships. By coming together to take action, participants not only increased shade and biodiversity but also supported a sense of hope and reduced climate-related stress. Over time, these trees will serve as a carbon sink while enriching the local ecosystem for everyone to enjoy
2023 Climate Action Grant Recipients
- Image

- Project: Public Produce Project
- Grant: $ 1,900
- Project Description: Mount Paul Community Food Centre expanded its educational garden with new fruit trees and native bushes, creating a vibrant space that promotes local food, home gardening, and access to healthy produce. Open to the public, the garden demonstrates how community-led initiatives can strengthen food security and sustainability right here at home.
- Image

- Project: Stewardship: Living Sustainably Support the Wellbeing of Self, Community and the Earth Project
- Grant: $ 1,750
- Project Description: Students took the lead on water conservation by installing a rain barrel and drip irrigation system for their school garden. The initiative grew school-wide participation in sustainability, adding new compost bins in classrooms and a composter for garden waste. Thanks to a partnership with the SD73 Aboriginal Education Department, every student also received a reusable water bottle, helping cut down on single-use plastics and inspire everyday climate action.
- Image

- Project: Butler Urban Farm, Education and Healthy Urban Ecosystems and Circular Waste Systems Project
- Grant: $ 1,750
- Project Description: Schools, community groups, and residents took part in interactive workshops and farm visits that brought sustainable living to life — from harvesting produce and planting seedlings to creating snacks with fresh ingredients and making nature-inspired art. Additional sessions on native seed saving, botanical distillation, and garden trellis building deepened participants’ knowledge. New educational signs now guide visitors through self-led tours, showcasing the farm’s role in promoting healthy urban ecosystems and composting.
- Image

- Project: Kamloops Community Forest Project
- Grant: $ 1,074.74
- Project Description: Community members came together for a planting event with educational booths, family activities, and refreshments, fostering both connection and climate action. Participants helped plant a trembling aspen and native rough fescue grasses, followed by a second event to add more trees — boosting carbon absorption, biodiversity, and community pride in caring for local green spaces.
- Image

- Project: Grow Wild: Learning Cohort Project
- Grant: $ 1,750
- Project Description: The Kamloops Naturalists brought together over 100 residents to learn about native plant landscaping, sharing plant materials, seeds, and expert advice through community workshops and outreach events. A special presentation by Eva Durance, author of Cultivating the Wild, inspired attendees to rethink their gardens with local ecology in mind. Partnering with the Thompson-Shuswap Master Gardeners, the group also created a native plant guide to help Kamloops gardeners choose species that support biodiversity and climate resilience.
- Image

- Project: Composting at l’Ecole Elementaire South Sahali Project
- Grant: $ 1,204.59
- Project Description: Students and teachers teamed up to cut down on solid waste through a hands-on school composting
- program. Nine classrooms and the staff room joined in, with the Leadership Group taking charge of collecting compost and managing weekly pickups. To boost awareness, students created educational posters highlighting what belongs in recycling and compost bins — inspiring the whole school community to think differently about waste.
- Image
- Project: Sustainability Stories Project
- Grant: $ 1,200.06
- Project Description: Three new sustainability stories were added to the existing audio tour, inviting locals and visitors to explore by foot, bike, or transit — or listen online. These stories help people connect with the urban environment and reflect on how development choices shape our relationship with the land and with each other.
- Image

- Project: Repair Café Events
- Grant: $ 1,980
- Project Description: Skilled volunteers helped residents troubleshoot and repair household items, keeping them out of the landfill. Four Repair Café events were hosted, with 65% of repairs successful, along with a demonstration session and outreach at the Farmers’ Market and Memorial Cup Sustainability Expo. Volunteers were celebrated at a special appreciation event, highlighting the impact of community-driven waste reduction.
- Image
- Project: Zero Waste at the Market Project
- Grant: $ 1,550
- Project Description: The Farmers’ Market introduced waste stations and a pack-it-in, pack-it-out approach, encouraging vendors to switch to compostable and reusable packaging. A TRU practicum student also worked with vendors to share waste-reduction strategies, helping increase diversion rates and move the market closer to achieve their zero waste goal.
- Image

- Project: Pollinators Garden Project
- Grant: $ 855.07
- Project Description: This project increased natural wildflowers to support pollinators, improving pollination for rural crops and urban gardens. It also created a Monarch Butterfly oasis at the Kamloops Wildlife Park near the Education Centre, providing food, water, and shelter along migration routes.



